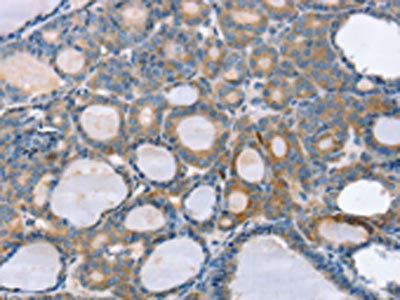

SLC25A1 Antibody
-
中文名稱:SLC25A1兔多克隆抗體
-
貨號:CSB-PA564826
-
規格:¥1100
-
圖片:
-
The image on the left is immunohistochemistry of paraffin-embedded Human thyroid cancer tissue using CSB-PA564826(SLC25A1 Antibody) at dilution 1/25, on the right is treated with fusion protein. (Original magnification: ×200)
-
The image on the left is immunohistochemistry of paraffin-embedded Human liver cancer tissue using CSB-PA564826(SLC25A1 Antibody) at dilution 1/25, on the right is treated with fusion protein. (Original magnification: ×200)
-
-
其他:
產品詳情
-
Uniprot No.:
-
基因名:
-
別名:Citrate transport protein antibody; CTP antibody; mitochondrial antibody; SLC20A3 antibody; Slc25a1 antibody; solute carrier family 20 (mitochondrial citrate transporter), member 3 antibody; solute carrier family 25 (mitochondrial carrier, citrate transporter), member 1 antibody; Solute carrier family 25 member 1 antibody; Tricarboxylate carrier protein antibody; Tricarboxylate transport protein antibody; tricarboxylate transport protein, mitochondrial antibody; TXTP_HUMAN antibody
-
宿主:Rabbit
-
反應種屬:Human,Mouse,Rat
-
免疫原:Fusion protein of Human SLC25A1
-
免疫原種屬:Homo sapiens (Human)
-
標記方式:Non-conjugated
-
抗體亞型:IgG
-
純化方式:Antigen affinity purification
-
濃度:It differs from different batches. Please contact us to confirm it.
-
保存緩沖液:-20°C, pH7.4 PBS, 0.05% NaN3, 40% Glycerol
-
產品提供形式:Liquid
-
應用范圍:ELISA,IHC
-
推薦稀釋比:
Application Recommended Dilution ELISA 1:2000-1:5000 IHC 1:25-1:100 -
Protocols:
-
儲存條件:Upon receipt, store at -20°C or -80°C. Avoid repeated freeze.
-
貨期:Basically, we can dispatch the products out in 1-3 working days after receiving your orders. Delivery time maybe differs from different purchasing way or location, please kindly consult your local distributors for specific delivery time.
-
用途:For Research Use Only. Not for use in diagnostic or therapeutic procedures.
相關產品
靶點詳情
-
功能:Citrate transporter that mediates the exchange of mitochondrial citrate for cytosolic malate. Also able to mediate the exchange of citrate for isocitrate, phosphoenolpyruvate, cis- but not trans-aconitate and to a lesser extend maleate and succinate. Important for the bioenergetics of hepatic cells as it provides a carbon source for fatty acid and sterol biosyntheses, and NAD(+) for the glycolytic pathway. Required for proper neuromuscular junction formation.
-
基因功能參考文獻:
- SLC25A1 and ACLY upregulation suggests that metabolic reprogramming in Behcet's syndrome involves the citrate pathway dysregulation. PMID: 30050389
- tested the expression specificity of the Cochlin-tomoprotein by testing blood and CSF samples. The concentration was below the detection limit (0.2 ng/ml) in 38 of the 40 blood, and 14 of the 19 CSF samples PMID: 29377917
- Pathogenic mutations of the human mitochondrial citrate carrier SLC25A1 lead to impaired citrate export required for lipid, dolichol, ubiquinone and sterol synthesis. PMID: 29031613
- this study shows increased expression of SLC25A1 gene in cells from children with Down syndrome PMID: 27502741
- Altered metabolism in 22qDS reflected a critical role for the haploinsufficiency of the mitochondrial citrate transporter SLC25A1, further enhanced by HIF-1alpha, MYC, and metabolite controls. PMID: 26221035
- we report for the first time on a patient with a genetically confirmed diagnosis of SLC25A1 deficiency and treatment with either malate or citrate PMID: 24687295
- SLC25A1 has a key role in TNF-alpha and IFNgamma induced inflammation and is induced at the transcriptional level by these two inflammation mediators cytokines. PMID: 25072865
- We report for the first time a patient with a mitochondrial citrate carrier deficiency. Our data support a role for citric acid cycle defects in agenesis of corpus callosum PMID: 23393310
- Compares and contrasts all the known human SLC25A* genes and includes functional information. PMID: 23266187
- Deficiency in SLC25A1, encoding the mitochondrial citrate carrier, causes combined D-2- and L-2-hydroxyglutaric aciduria. PMID: 23561848
- The mitochondrial citrate carrier (CIC) is present and regulates insulin secretion by human male gamete. PMID: 22355067
- muscular symptoms of CTP deficiency respond to creatine supplementation PMID: 21660517
- The mitochondrial citrate carrier: a new player in inflammation PMID: 21787310
- The results of molecular cloning of a citrate transporter from human normal prostate epithelial PNT2-C2 cells, is reported. PMID: 20448665
- Results suggest an evolutionary conserved role for Sea/SLC25A1 in the regulation of chromosome integrity. PMID: 19654186
- These results show that methylation, histone acetylation and Sp1 are important in the transcriptional regulation of the CIC proximal promoter. PMID: 18706393
- These results show that FOXA plays a role in the transcriptional regulation of CIC and in insulin secretion. PMID: 19445897
- CIC silencer activity extends over 26 bp (-595/-569), which specifically bind a protein ZNF224 present in HepG2 cell nuclear extracts. PMID: 19505435
顯示更多
收起更多
-
相關疾病:Combined D-2- and L-2-hydroxyglutaric aciduria (D2L2AD)
-
亞細胞定位:Mitochondrion inner membrane; Multi-pass membrane protein.
-
蛋白家族:Mitochondrial carrier (TC 2.A.29) family
-
數據庫鏈接:
Most popular with customers
-
-
YWHAB Recombinant Monoclonal Antibody
Applications: ELISA, WB, IHC, IF, FC
Species Reactivity: Human, Mouse, Rat
-
Phospho-YAP1 (S127) Recombinant Monoclonal Antibody
Applications: ELISA, WB, IHC
Species Reactivity: Human
-
-
-
-
-